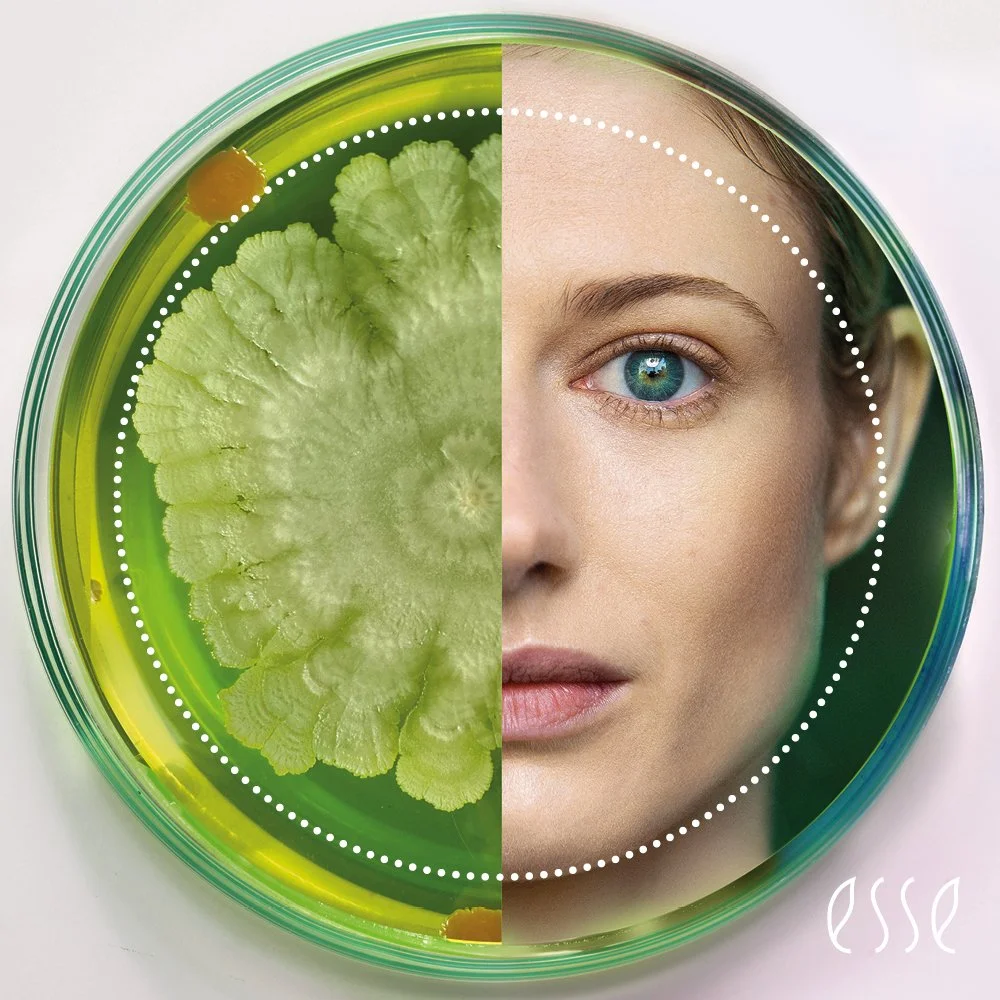
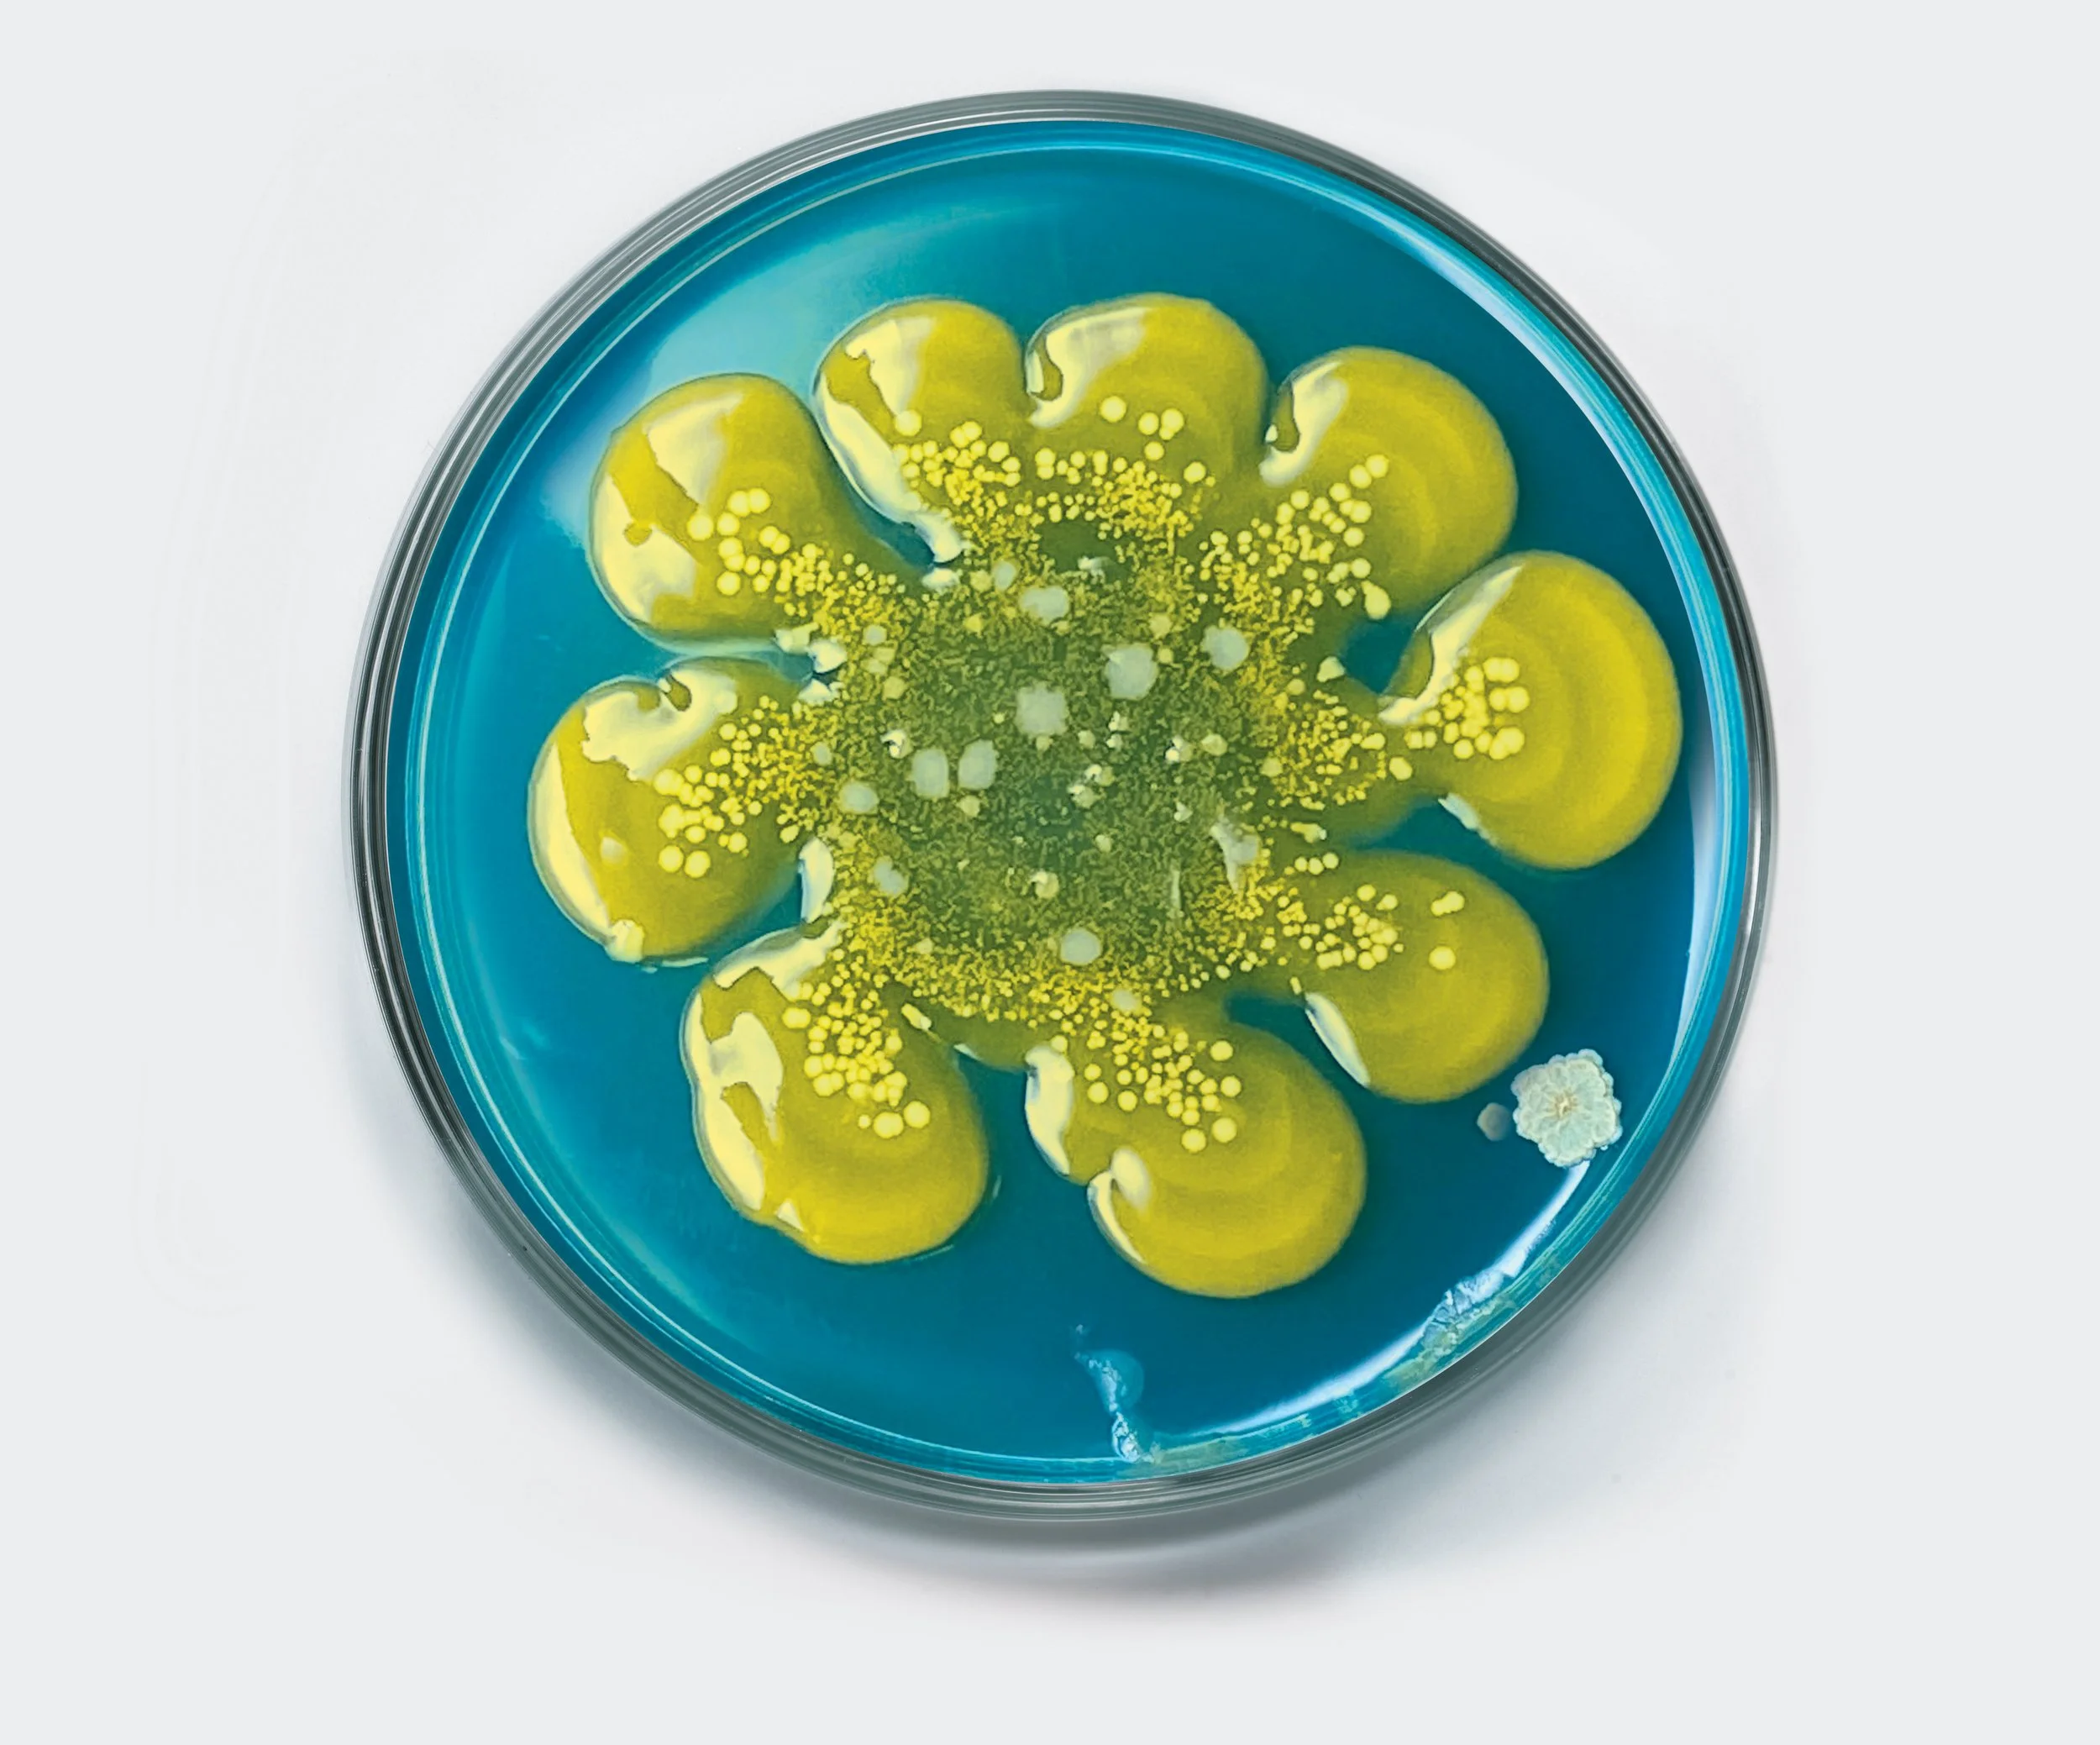
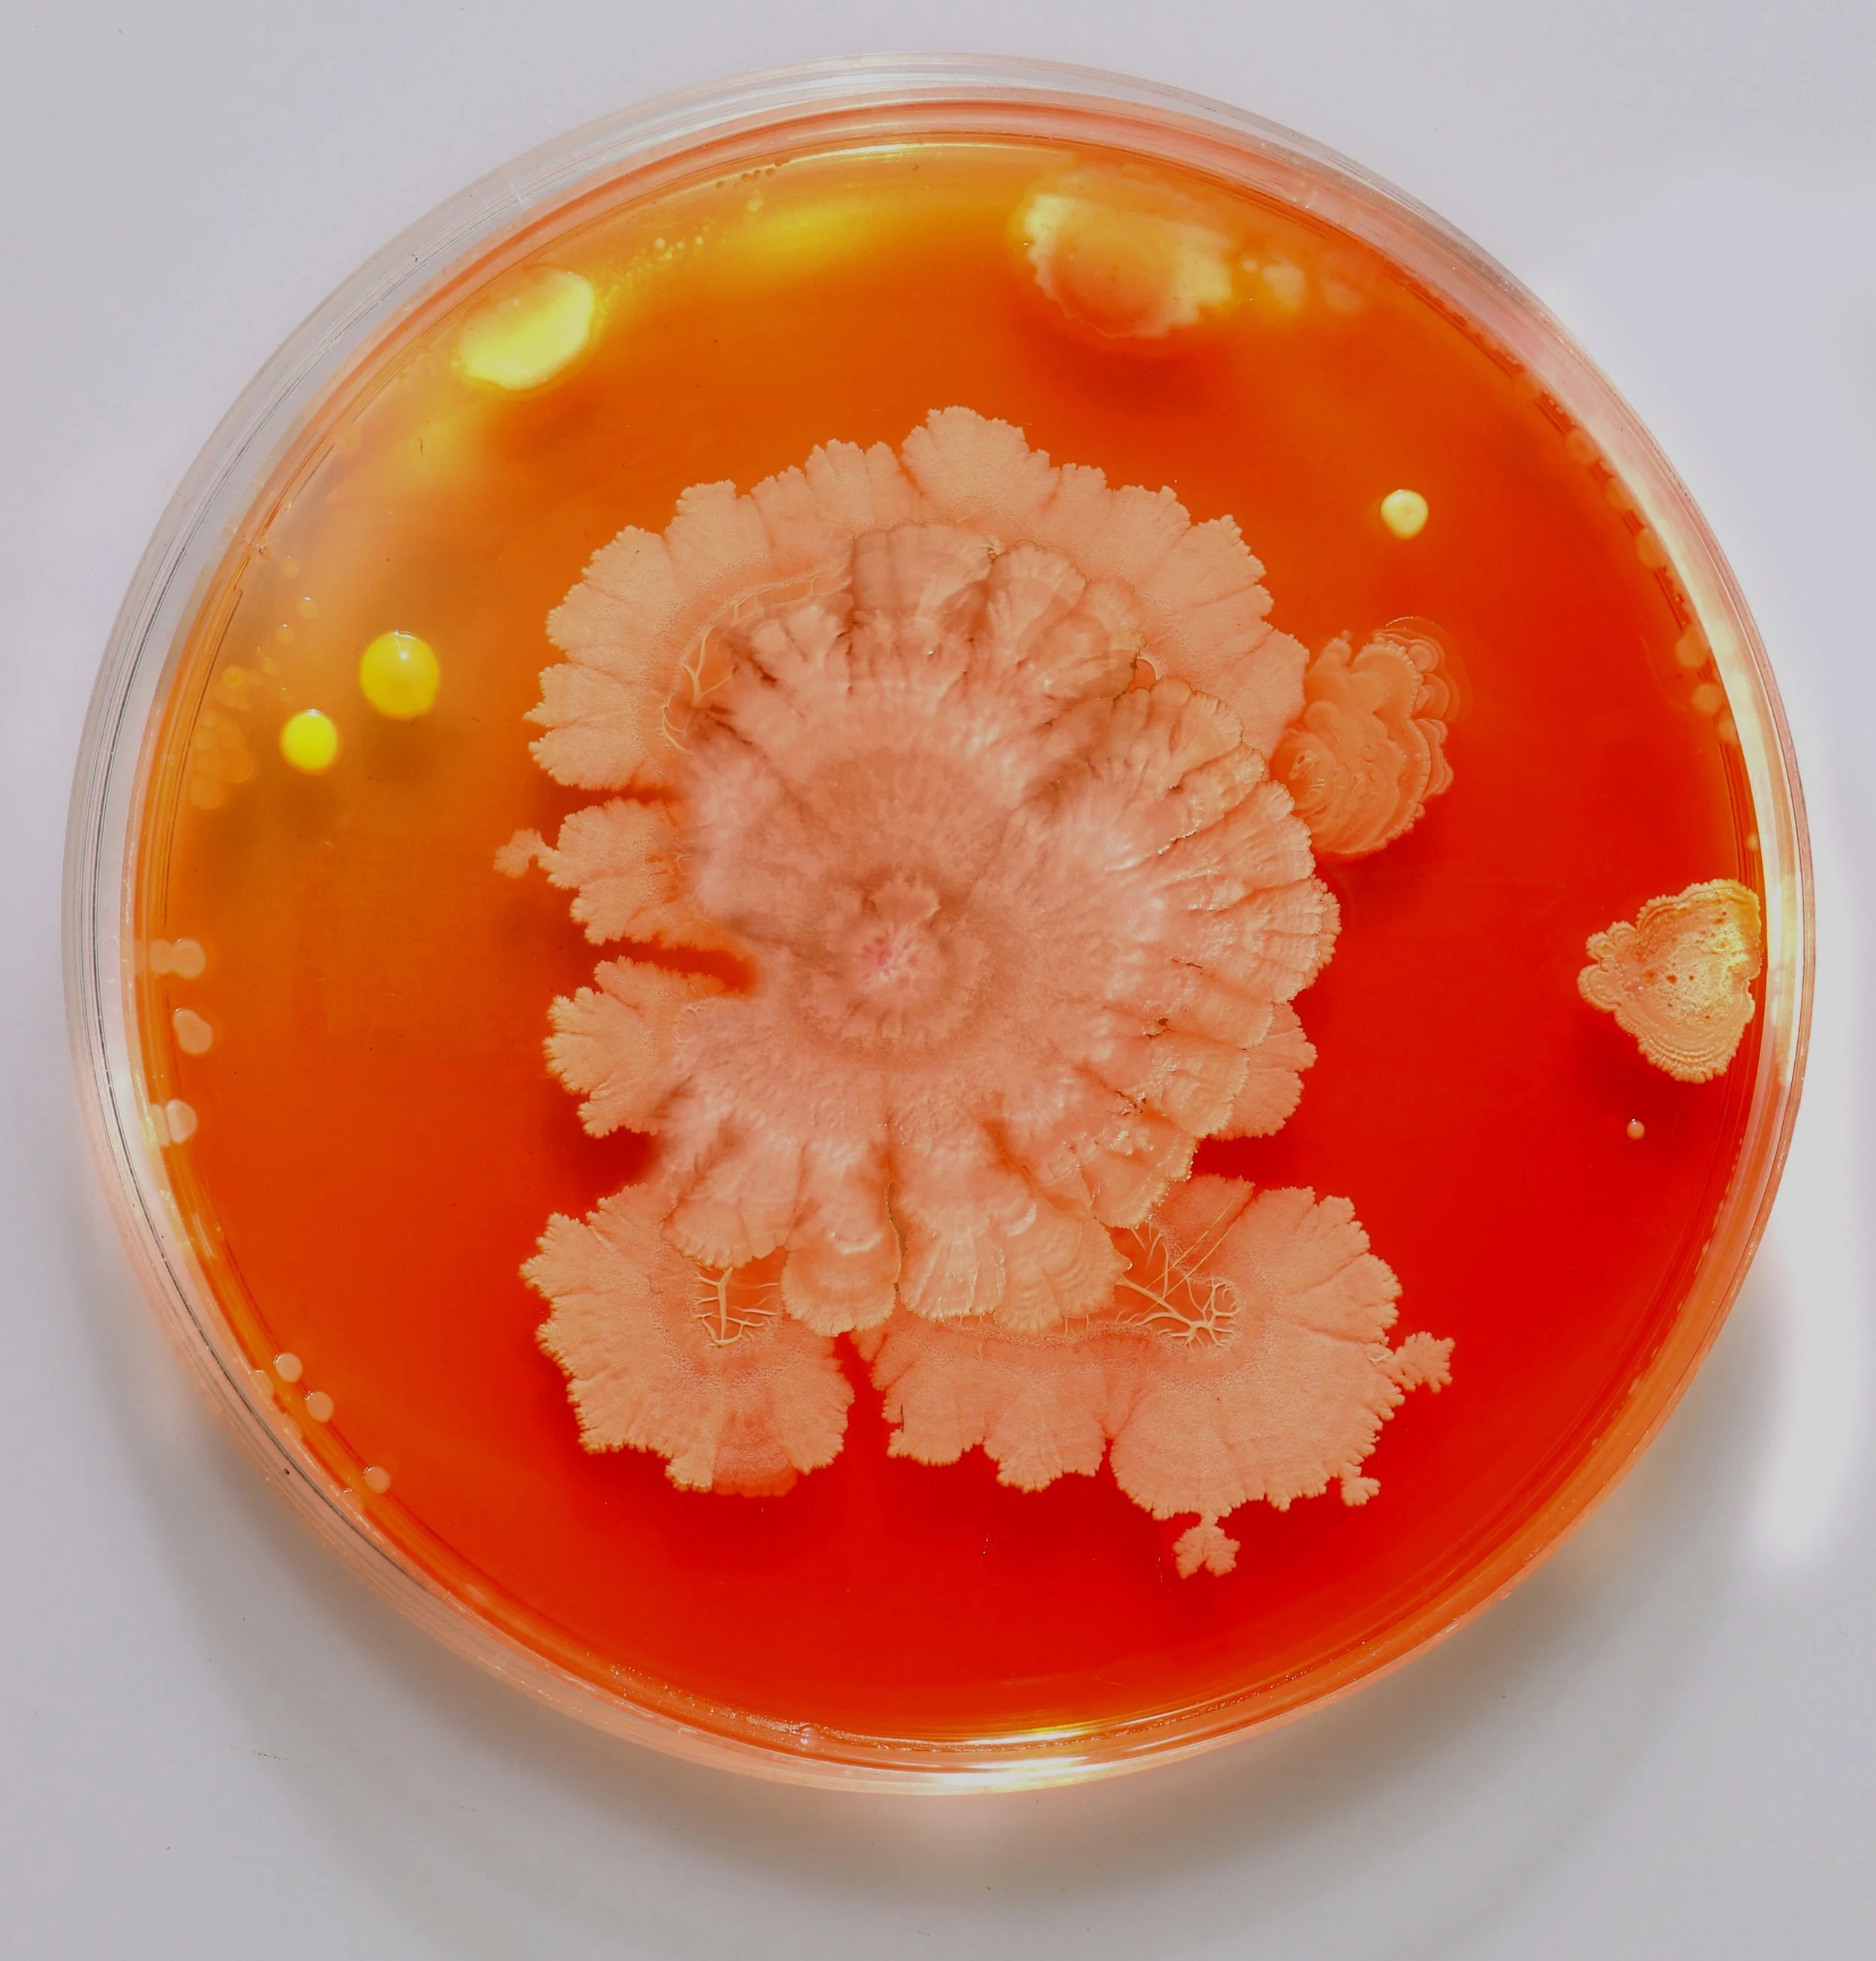

Discover Radiant Skin with Esse: The Power of Organic Probiotic Skincare!
“In the last few years I have become fascinated and ever-so slightly obsessive about all things pure and natural, from the food I eat to most recently the skincare I use. So I decided to start researching and trialing organic skincare products, in the hope of finding the perfect brand for my clients!!”
ARE YOU READY TO SAY GOODBYE TO HARSH CHEMICALS?
And hello to nature’s very own skincare superheroes.
Meet Esse Skincare - the organic, probiotic-infused brand that’s changing the way we care for our skin.
If you’re tired of the same old commercial products that promise miracles but deliver irritation, it’s time to explore a cleaner, greener, and more effective approach to beauty.
The Organic Probiotic Advantage
Unlike typical chemical-laden skincare that often relies on synthetic ingredients, Esse Skincare harnesses the power of nature.
Here’s what sets Esse apart:
• Organic Goodness: Every formula is crafted with organically sourced ingredients, free from pesticides and harsh additives. This means you’re feeding your skin with pure, nutrient-rich botanicals that soothe and rejuvenate.
• Probiotic Power: Our skin is home to millions of microorganisms that keep our natural barrier in check. Esse’s probiotic-infused products work to balance your skin’s microbiome, helping to reduce inflammation, fend off irritants, and promote a naturally radiant complexion.
• Gentle Yet Effective: While commercial chemical products can sometimes do more harm than good—disrupting your skin’s delicate balance and causing sensitivity—Esse Skincare delivers visible results without the side effects. It’s skincare that works in harmony with your body.
• Hydration & Barrier Repair: Organic ingredients and probiotics team up to lock in moisture and repair your skin’s barrier, leaving it smoother, plumper, and more resilient.
• Soothing & Calming: If you’ve been battling redness, irritation, or breakouts, the gentle formulations of Esse can help calm inflamed skin—no more harsh reactions to synthetic irritants.
• Naturally Radiant: Over time, Esse Skincare works to even out your skin tone and boost its natural radiance. It’s not about masking imperfections—it’s about giving you the confidence to glow from within.
It’s not just better for you, it’s better for the Planet too!
Choosing Esse isn’t just a win for your skin, it’s a win for the environment too. With sustainably sourced ingredients and eco-friendly practices, Esse Skincare is committed to a healthier planet.
When you choose organic probiotic skincare, you’re investing in a future where beauty and sustainability go hand in hand.
Ready for a Skin Transformation?
The future of skincare is here, and it’s organic, potent, and designed just for you.
Embrace a regimen that respects your skin’s natural balance and helps you achieve the glowing, healthy skin you deserve.
Discover the Esse difference.
Try organic probiotic skincare and join the revolution of naturally radiant skin.
Experience the glow that only nature can create.
Your skin and the planet, will thank you!
Scientifically formulated skincare for all skin types – with prebiotics, probiotics and active ingredients to help restore your skin’s microbiome.